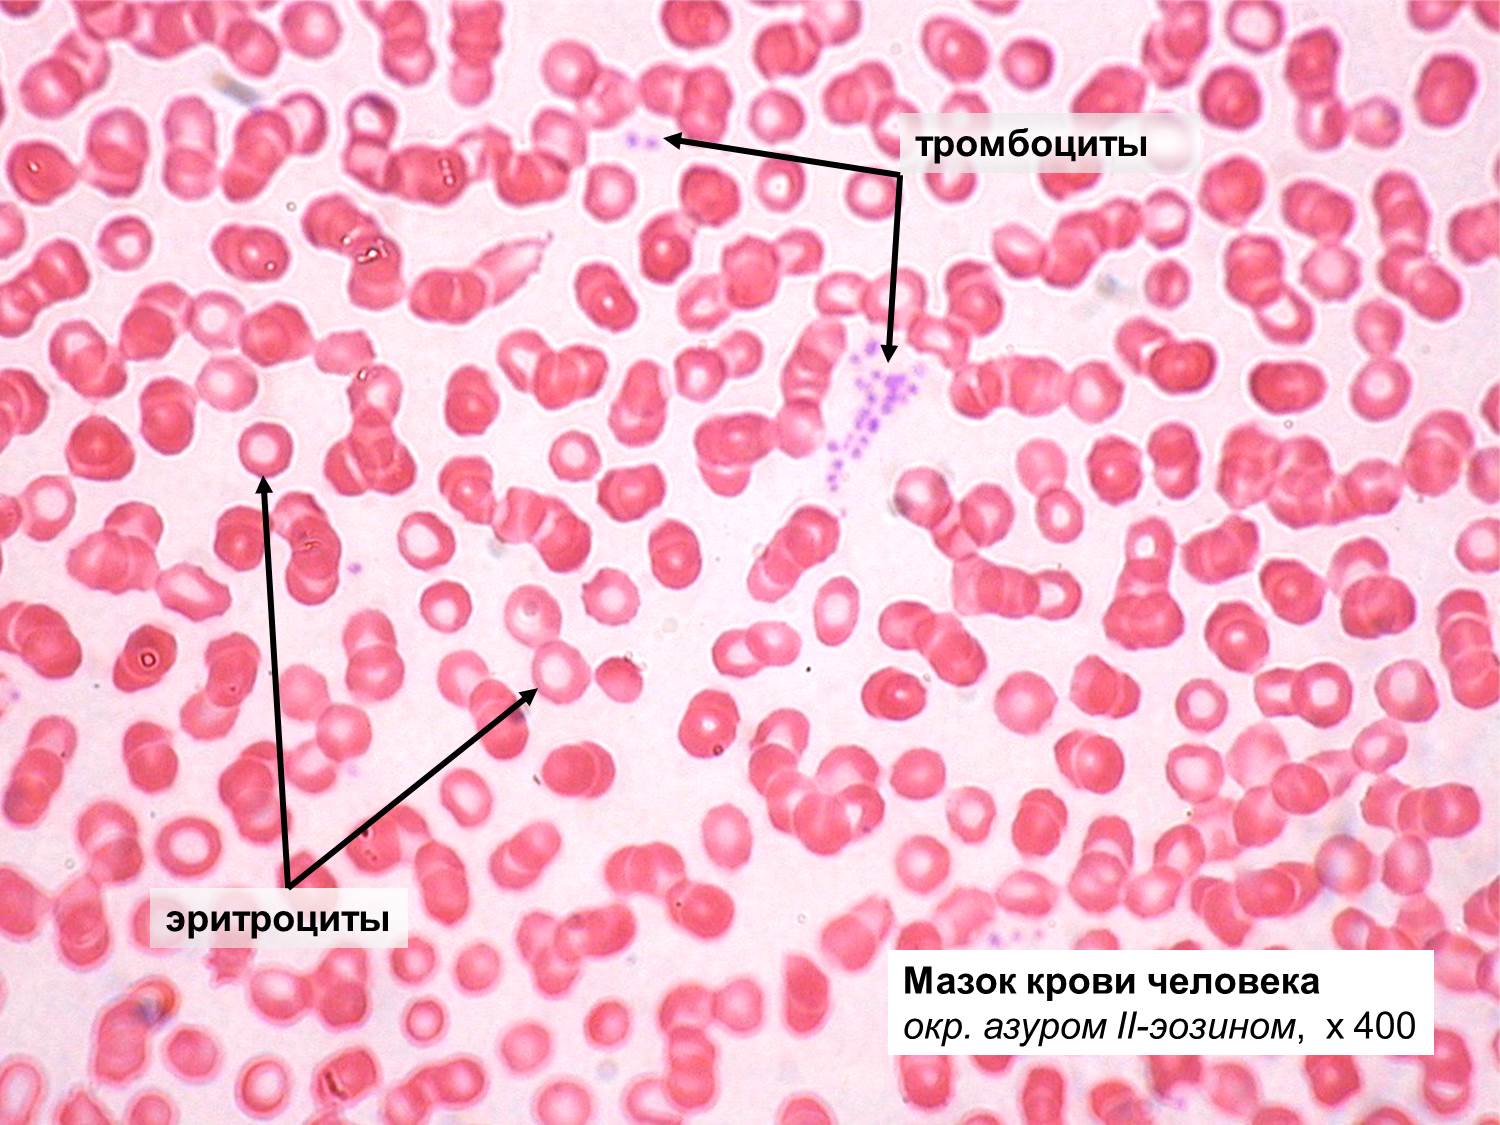

Снижение тромбоцитов и эритроцитов
Рецепты крампетов в токе боке бесплатная версия
Tortoise перевод с английского
Плашки пкр
Музыкальные сайты с музыкой
Клей пена 28
Как изменить config
Доктор шишонин гипертония без лекарств
Admire rp
Закрытые поры на лице как
4 степень повреждения волос
Чувства меча 116
Карты игры шаблон
Согласно содержания обращения
Снижение тромбоцитов и эритроцитов 112 фото